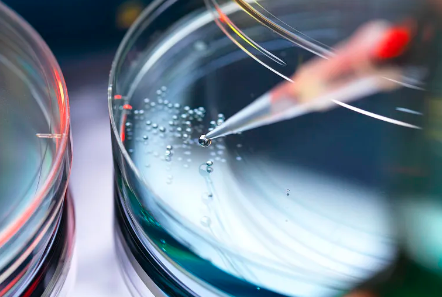
image.png

廣州艾樂貝拉干細(xì)胞資質(zhì)齊全嗎?服務(wù)怎樣?
2024-10-12 17:05:11 來源: 小編 咨詢醫(yī)生
本文將圍繞這個(gè)話題,從專業(yè)角度對(duì)廣州艾樂貝拉干細(xì)胞的資質(zhì)及服務(wù)進(jìn)行詳細(xì)分析。
首先,我們來了解一下干細(xì)胞技術(shù)。干細(xì)胞技術(shù)是一種具有廣泛應(yīng)用前景的生物技術(shù),可以應(yīng)用于治療各種疾病,例如血液病、心臟病、糖尿病等。在我國(guó),對(duì)干細(xì)胞技術(shù)的研發(fā)和應(yīng)用有著嚴(yán)格的規(guī)定和監(jiān)管。
廣州艾樂貝拉干細(xì)胞生物科技有限公司,是一家專注于干細(xì)胞技術(shù)研發(fā)和應(yīng)用的企業(yè)。那么,該公司的干細(xì)胞資質(zhì)是否齊全呢?
根據(jù)我國(guó)相關(guān)法律法規(guī),干細(xì)胞研發(fā)企業(yè)必須具備以下資質(zhì):
1.生物醫(yī)藥研發(fā)企業(yè)資質(zhì);2.干細(xì)胞研發(fā)專項(xiàng)許可;3.GMP(藥品生產(chǎn)質(zhì)量管理規(guī)范)認(rèn)證。通過查詢相關(guān)資料,廣州艾樂貝拉干細(xì)胞生物科技有限公司已具備上述資質(zhì),可以合法從事干細(xì)胞研發(fā)和應(yīng)用。
在了解了廣州艾樂貝拉干細(xì)胞的資質(zhì)后,我們來關(guān)注一下該公司的服務(wù)質(zhì)量。
1.技術(shù)實(shí)力:廣州艾樂貝拉干細(xì)胞擁有一支高水平的研發(fā)團(tuán)隊(duì),團(tuán)隊(duì)成員具備豐富的干細(xì)胞研發(fā)經(jīng)驗(yàn)。此外,公司還與國(guó)內(nèi)外多家知名科研機(jī)構(gòu)建立了戰(zhàn)略合作關(guān)系,確保了公司在干細(xì)胞技術(shù)領(lǐng)域的領(lǐng)先地位。
2.產(chǎn)品質(zhì)量:公司嚴(yán)格按照GMP標(biāo)準(zhǔn)進(jìn)行生產(chǎn),確保干細(xì)胞產(chǎn)品質(zhì)量。同時(shí),公司對(duì)產(chǎn)品質(zhì)量進(jìn)行嚴(yán)格檢測(cè),確保為客戶提供安全、有效的干細(xì)胞產(chǎn)品。
3.服務(wù)水平:廣州艾樂貝拉干細(xì)胞為客戶提供全方位的服務(wù),包括干細(xì)胞存儲(chǔ)、干細(xì)胞制備、干細(xì)胞治療等。公司秉承“客戶至上”的服務(wù)理念,以專業(yè)的態(tài)度為客戶提供個(gè)性化、精準(zhǔn)的干細(xì)胞治療方案。
4.用戶評(píng)價(jià):通過調(diào)查了解到,廣州艾樂貝拉干細(xì)胞在客戶中有著良好的口碑。許多客戶表示,公司服務(wù)質(zhì)量高,工作人員專業(yè)熱情,讓人放心。
綜上所述,廣州艾樂貝拉干細(xì)胞生物科技有限公司在資質(zhì)方面齊全,且服務(wù)質(zhì)量較高。當(dāng)然,作為一家致力于干細(xì)胞技術(shù)研發(fā)和應(yīng)用的企業(yè),廣州艾樂貝拉干細(xì)胞還需不斷創(chuàng)新,提高自身競(jìng)爭(zhēng)力,為客戶提供更優(yōu)質(zhì)的服務(wù)。
最后,提醒大家在選擇干細(xì)胞服務(wù)時(shí),要充分了解企業(yè)的資質(zhì)、技術(shù)實(shí)力、產(chǎn)品質(zhì)量等方面,確保自己的權(quán)益得到保障。同時(shí),也希望我國(guó)干細(xì)胞產(chǎn)業(yè)能夠健康發(fā)展,為更多患者帶來福音。
- 2024-09-19沛縣干細(xì)胞捐贈(zèng)機(jī)構(gòu)有哪些,附機(jī)構(gòu)名單
- 2024-07-23北京301醫(yī)院干細(xì)胞,北京301干細(xì)胞移植怎么樣
- 2024-07-23鼓樓醫(yī)院干細(xì)胞,鼓樓醫(yī)院干細(xì)胞移植費(fèi)用
- 2024-11-02蘭州哪家醫(yī)院干細(xì)胞捐獻(xiàn)流程最完善?捐獻(xiàn)過程有哪些注意事項(xiàng)?
- 2024-10-25禪城醫(yī)院干細(xì)胞專家有哪些?治療成功率如何?
- 2024-09-15長(zhǎng)春干細(xì)胞醫(yī)院哪家好,上榜前十名單公布
- 2024-10-10干細(xì)胞海河醫(yī)院治療成果如何?一文揭秘
- 2024-07-24干細(xì)胞的作用和功效能管幾年,干細(xì)胞對(duì)人體有什么好處
- 2024-09-07造血干細(xì)胞移植后食譜及注意事項(xiàng)
- 2024-09-05我國(guó)干細(xì)胞制備技術(shù)發(fā)展現(xiàn)狀
- 2024-09-20打干細(xì)胞抗衰老有副作用嗎
- 2024-10-11干細(xì)胞注射抗衰老真的有效嗎?有哪些潛在風(fēng)險(xiǎn)?
- 2024-09-16干細(xì)胞注射幾次效果好呢,干細(xì)胞治療療程和時(shí)間
- 2024-09-21干細(xì)胞填淚溝效果好嗎,可以保持多久
- 2024-09-12干細(xì)胞效果可持續(xù)多久,干細(xì)胞一針維持多久
- 2024-09-09脂肪干細(xì)胞價(jià)格,國(guó)內(nèi)各類干細(xì)胞費(fèi)用參考
- 2024-09-25美國(guó)干細(xì)胞心臟療法怎么樣,進(jìn)展情況分析
- 2024-09-28如何看待干細(xì)胞的抗衰老潛力?
